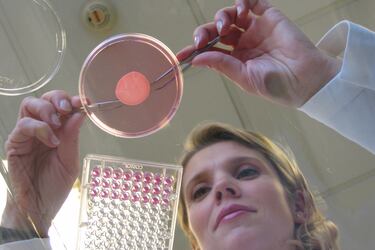

Crear un colchón reciclable no es algo que se produce de la noche a la mañana. En la tecnología del colchón Excellence de CIC hay 100 años de historia, resortes en espiral, marcos de espuma y cubiertas resistentes a la formación de las clásicas "bolitas". Acá te contamos más sobre su tecnología.
1 oct 2024 01:51 PM